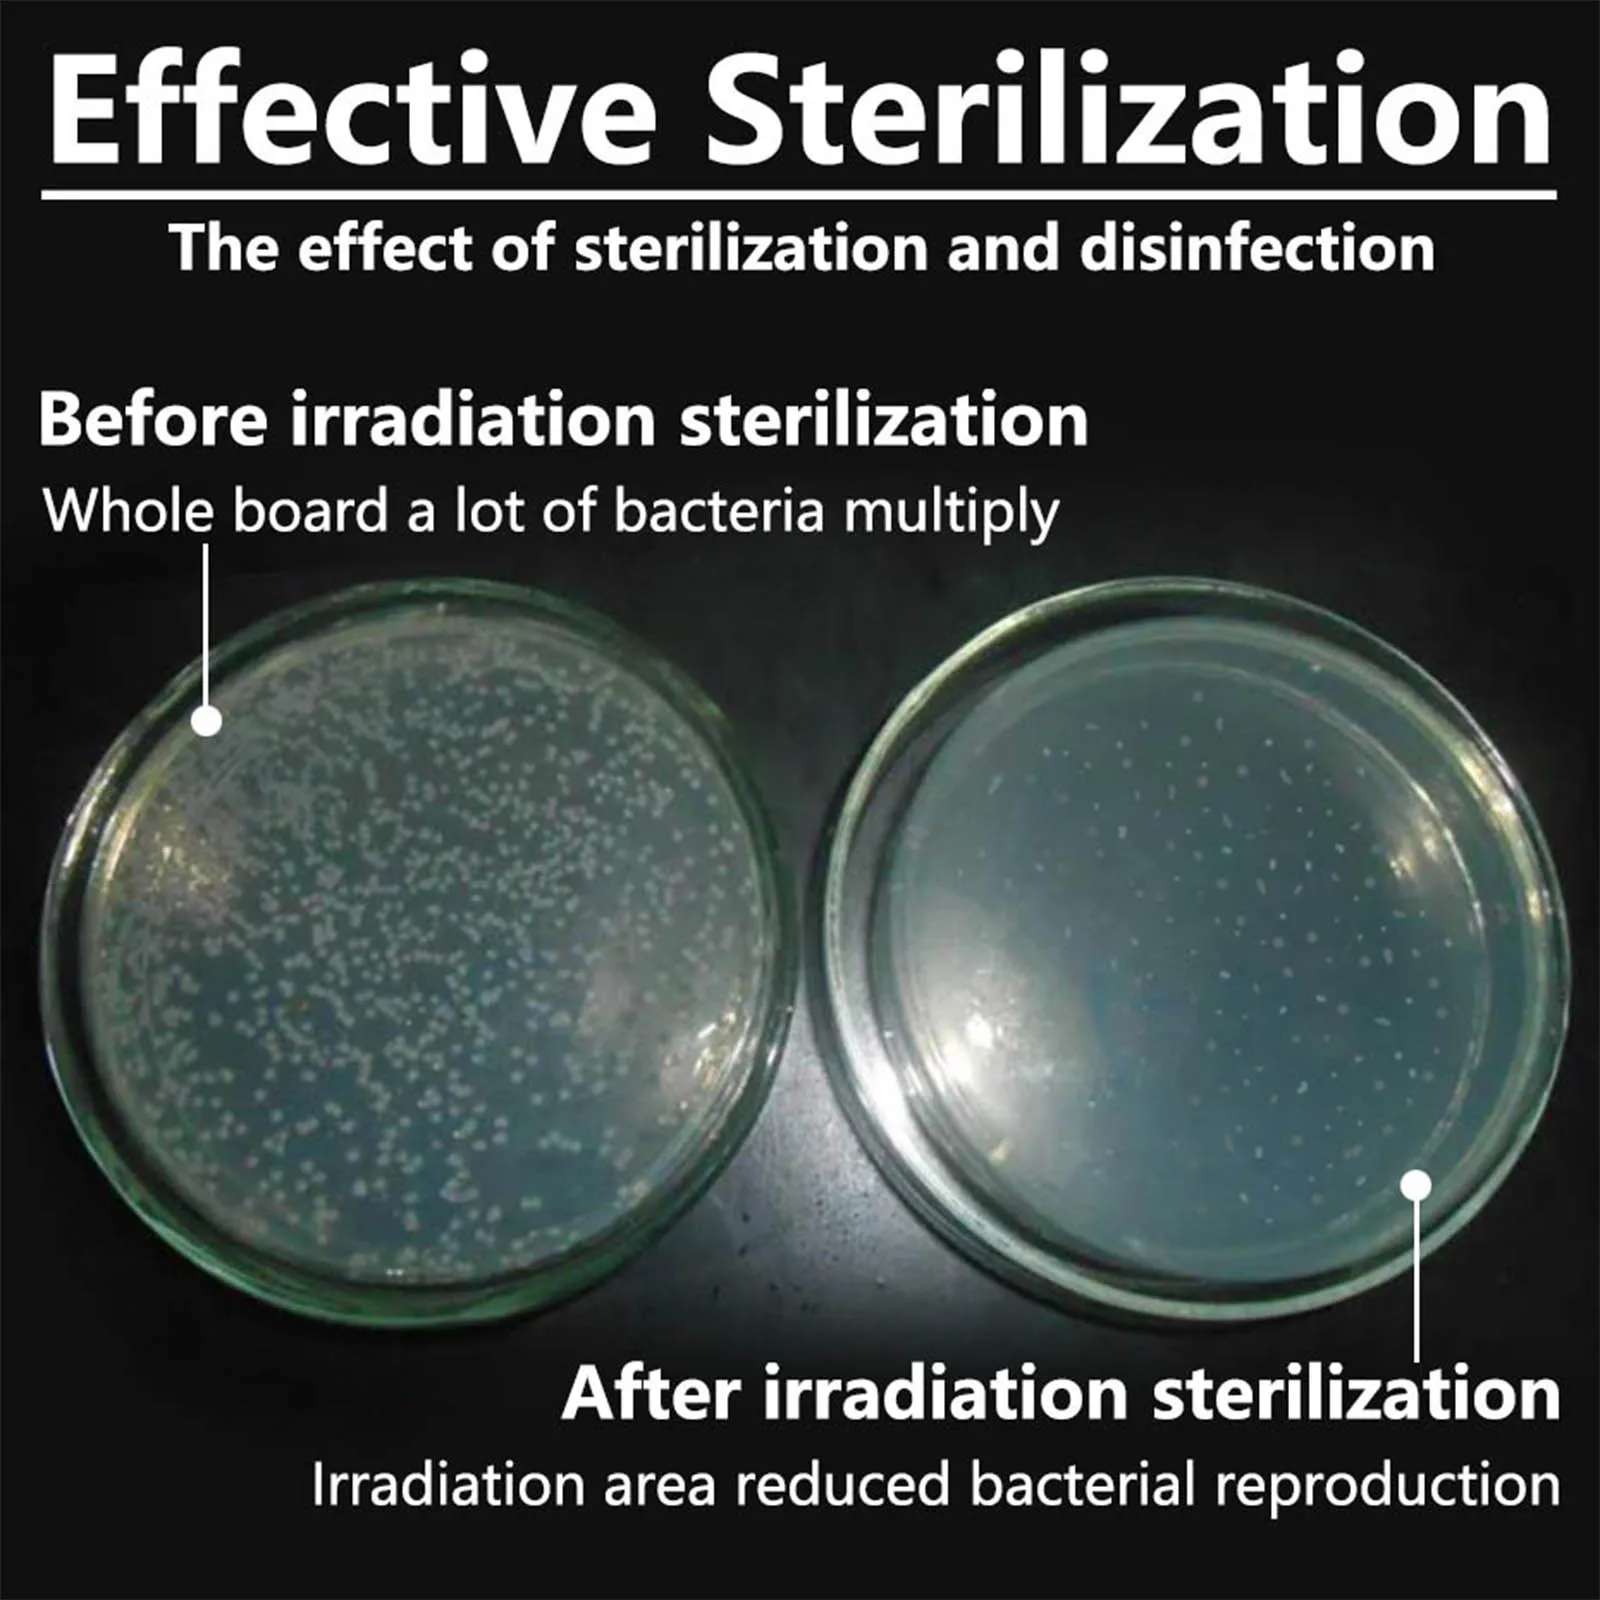
thumb

UV UVC LED Module 0.6W 3W 3535 6565 High Power Chip Light Beads Deep Ultra Violet Purple Diode Flashlight Part Accessory DIY
График изменения цены & курс обмена валют
Пользователи также просматривали

$2.10
1 шт. аксессуары для экскаваторов, пригодные для экскаватора Komatsu 60 200 210 220 240 300 360-6-7-8 крышка резервуара для воды аксессуары для крышки радиатора
aliexpress.ru
$1.48
Simulated Coral Wall Aquarium Decor PVC Artificial Plants Creative Tank Decoration for Home Office Fish Tanks Wear Resistant
aliexpress.ru
$2.67
Reptile Climbing Platform Durable Environmental Friendly Turtle Slope Platform Easy Clean Aquarium Terrarium Decor Accessories
aliexpress.ru
$65.75
For Mercedes Benz PHEV C Car clothing sun protection snow prevention antifreeze car protective cover auto cover
aliexpress.ru
$2.37
Очки для близорукости для мужчин и женщин, негабаритные квадратные очки с диоптриями в стиле ретро, с защитой от сисветильник, по рецепту
aliexpress.ru
$1.65
Home Decor Foam Christmas Berries New Artificial Simulation Decoration Christmas Red Fruit Decors Simulation Red Fruit Branches
aliexpress.com
$8.84
Mother's Day Flower Box Empty Flower Gift Box Can Place Surprise Gifts Candies Flowers N9B7
aliexpress.com
$18.90
Papua New Guinea Solomon Islands 3D Fashion Printed Slim Hoodies Dress Women Casual Wear Long Sleeve Hooded Sweatshirt Pullover
aliexpress.com
$8.61
16 20mm Hose Pipe Filter Car Wash Garden Irrigation Filters Sprayer Pump Filtering Net Strainer Stainless Steel Mesh Filter
aliexpress.com
$128.35
Made in China Air Conditioner Controller 11N6-90031 For Hyundai R210-7 R110-7 AC Control Part
aliexpress.com
$206.01
TD04 turbo 49477-01510 49477-01500 25187703 Turbocharger for Chevrolet Orlando Cruze Captiva Opel Antara 2.0 CDTI Engine
aliexpress.com
$31.50
18650 Li ion battery 12V 40ah 3s10p 12.6V 40000mah is used for xenon lamp of inverter, solar street lamp is used for vehicle ins
aliexpress.ru
$7.38
Набор из 2 Т-образных винтов LICG и пластиковой ручки M8, металлический быстродействующий зажим для Т-образных пазов, Т-образных треков, деревообрабатывающий инструмент «сделай сам»
aliexpress.ru
$5.40
5pcs Artificial Flowers Romantic Rose Silicone Real Touch High Quality Bouquet Luxury Decor Home Wedding Living Room Latex Fake
aliexpress.ru
$4.28
Двойные сумки на плечо, портативный рюкзак для покупок, холщовый рюкзак на шнурке, 2024, женский модный повседневный органайзер для путешествий, 3D узор
aliexpress.ru
$3,098.06
Хрустальная люстра Bohemia Ivele Crystal 2101H201/8/100IV/Y1 GB, 2101H201/8/100IV/Y1 GB
svetlux.ru
$6.00
Girls Bead Tassel Female Pendant Double Layer Clavicle Chain Necklace Fashion Jewelry Choker золотой
joom.ru
$7.34
Мягкий теплый вязаный шарф для домашних животных S/M/L Зимний шарф для собак Домашний декор Шарф для кошек Кошки S красный/белый
joom.ru
$30.12
2022 with box jumpman 1 og 1s mens basketball shoes bordeaux heritage bred patent hyper royal university blue lucky green men sports women
dhgate.com
$242.95
men women shoe casual track 2 sneakers 19fw track2 white lace-up jogging sneakers 3m triple s chaussures walk e5an#, Black
dhgate.com
$47.48
Wooden Handle Manual Garlic Press Stainless Steel 304 Garlic Masher Garlic Peeler Garlic Masher Creative Kitchen Gadgets
aliexpress.com
$6.90
Practical 10 Pieces 10 x 21700 Li-Ion Battery 8.0Ah Sticker for DeWalt 18V 20V Lithium Battery Label Accessories DCB200 DCB203
aliexpress.com
$2.25
5pcs Pneumatic Quick Cannula Plug Head Trachea Quick Fittings Pipe Plug Push Fit Connector Plastic TPP6mm / 8mm / 10mm / 12mm
aliexpress.com
$75.95
Rugsx - Alfombra de pasillo KARMEL llanura, un color blanco 100 cm Blanco 100x200 cm
manomano.es
$1,974.36
Venticello, Muebles de baño, 404 x 1546 x 372 mm, modelo suspendido, En madera Vidrio Gris brillante
manomano.es
$16.13
cat toys electric rolling ball for cats interactive laser magic toy luminous with feather tumbler
dhgate.com
$4.33
Kinlion Classic Vintage Cat Eye Sunglasses Women Oversize Luxury Mens Sunglasses Brand Designer Sexy Woman Fashion 2019 Gafas
aliexpress.com
$92.63
Computer Chair Home Office Chair Modern Simple Conference Chair Staff Swivel Chair Bow Chair Mahjong Lift Chair
aliexpress.com
$12.82
10LED Solar Energy Powered Lights Outdoor Garden Street Highlight Lighting Waterproof Aluminum Alloy Wall Hanging Lamps
aliexpress.com
$495.99
Альтанка-гриль с твердым верхом 6,5x12 футов, уличная альтанка-барбекю с наклонной крышей из оцинкованной стали, металлический постоянный солнцезащитный козырек для гриля
aliexpress.ru
$17.44
Удлинитель UNIVersal с заземлением 30 м на рамке 2,2 кВт 1 розетка ПВС 3х0,75 кв.мм IP54, Оранжевый;серый
petrovich.ru
$3.66
Motorcycle Throttle Cable Guard Cover Protection For Husqvarna FC TC TE FE TX FX For KTM EXC EXCF SX SXF XC XCF XCFW 2016-2023
aliexpress.ru
$7.86
Капсулы из корня одуванчика — подходят для детоксикации и очищения печени, диаметики, способствующие добавки здоровья кишечника
aliexpress.ru
$88.75
Leecabe 26CM/10inches Snake PU Upper exotic High Heel platform party slipper sandals stripper heel Pole Dance shoes
aliexpress.ru
$3.44
Kids Toy PU Leather 60cm Doll Shoes Princess Bowknot Causal Wear Doll High Heel Shoes 7.8CM Handmade 1/3 Doll Shoes DIY Toy
aliexpress.ru
$38.74
Круглая бамбуковая доска для приготовления мясных изделий, 14 дюймов, 3 отделения, двухсторонний поднос с запирающейся крышкой, для пикников и мероприятий
aliexpress.ru